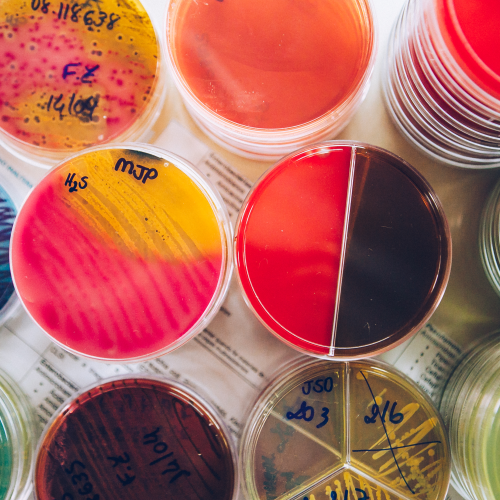

Laboratório Santa Clara
O Laboratório Santa Clara desde 1978 contribui para o crescimento e desenvolvimento econômico e social da região. Priorizando a excelência em atendimento e investindo sempre em equipamentos de última geração que proporcionam maior qualidade e precisão de análise clínica.
Desde a fundação do laboratório, era grande a preocupação dos Fundadores com a qualidade dos exames e o bom atendimento. Diante disso, em pouco tempo, o Laboratório Santa Clara já tinha o reconhecimento de seu trabalho no meio médico de Montes Claros - MG.
Com uma das melhores e mais modernas estruturas, o laboratório Santa Clara possui diversas unidades em Montes Claros e região, proporcionando atendimento humanizado, rapidez na coleta e na entrega dos exames, atenção com os nossos parceiros e clientes.
Confira nossos serviços e entre em contato com uma de nossas unidades, sempre perto de você!